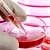

Yaza girerken bocavirus infeksiyonlarında belirgin artış görülüyor
 Güncel verilere göre, yaz aylarına girdiğimiz son dönemde, Bocavirus Tip-1 infeksiyonlarında belirgin bir artış gözlenmektedir. Gelişim Tıp Laboratuvarları’na, mültipleks PCR yöntemiyle solunum yolu mikrobik etkenlerini belirlemek istemiyle 2016 Nisan’da 53, Mayıs’ta 51 ve Haziran’ın 17’sine kadar da 44 olmak üzere, toplamda 148 hastadan solunum yolu örneği gönderilmiştir. Nisan ayında 53 hastadan yalnızca 1 (%1.9) Bocavirus Tip-1 görülürken, Mayıs ayında bu sayı 17 (%56.8)’e yükselmiştir. Haziran’da solunum yolu örneği gönderilen 44 hastadan 25’inde Bocavirus Tip-1 saptanmıştır. Mayıs ve Haziran ayları itibariyle, Bocavirus infeksiyonlarında belirgin bir artış gözlenmektedir.
Güncel verilere göre, yaz aylarına girdiğimiz son dönemde, Bocavirus Tip-1 infeksiyonlarında belirgin bir artış gözlenmektedir. Gelişim Tıp Laboratuvarları’na, mültipleks PCR yöntemiyle solunum yolu mikrobik etkenlerini belirlemek istemiyle 2016 Nisan’da 53, Mayıs’ta 51 ve Haziran’ın 17’sine kadar da 44 olmak üzere, toplamda 148 hastadan solunum yolu örneği gönderilmiştir. Nisan ayında 53 hastadan yalnızca 1 (%1.9) Bocavirus Tip-1 görülürken, Mayıs ayında bu sayı 17 (%56.8)’e yükselmiştir. Haziran’da solunum yolu örneği gönderilen 44 hastadan 25’inde Bocavirus Tip-1 saptanmıştır. Mayıs ve Haziran ayları itibariyle, Bocavirus infeksiyonlarında belirgin bir artış gözlenmektedir.
Bir salgın boyutundan da söz edilebilir. Çünkü, Nisan ayında hastaların %71.7’si, Mayıs’ta %49’u negatif sonuç verirken, Haziran’da bu oran %29.5’e düşmüş durumdadır. Haziran’da hastaların %70.5’i pozitif sonuç vermiştir. Bu oranı yükselten de Bocavirus’tur. Bocavirus, gönderilen 44 örneğin %56.8’inde pozitif bulunurken (25 vaka pozitif),toplamda 33 pozitif örneğin de %75’ini oluşturmaktadır.
Nisan ayında pozitif vakalarda üstünlük Influenza A, Influenza B ve H1N1 iken (20 pozitif vakanın 15’i), Mayıs ve Haziran aylarında üstünlük tümüyle Bocavirus infeksiyonuna geçmiş durumdadır. Haziran ayı itibariyle, yalnızca 1 hastada Influenza A, 1 hastada RSV-B, 1 hastada Parainfluneza-4, 1 hastada Rhino/Enterovirus, 2 hastada Adenovirus, 1 hastada Metapneumovirus, 2 hastada da Mycoplasma pneumoniae saptanmıştır.
Çalışma, mültipleks Real-Time PCR yöntemiyle yapılmaktadır. Bu yöntemle 18 virüs ve 4 atipik pnömoni etkeni bakteri (Klamidya, Legionella, Mikoplazma, Bordotella) saptanmaktadır. Virüsler içinde de Influenza A, B, H1N1, RSV-A ve B, Parainfluenza ¼, Coronavirus türleri, Rhino / Enterovirus, Adenovirus, Metapneumovirus ve Bocavirus Tip 1 bulunmaktadır. Kullanılan kit CE onaylıdır.
Bocavirus İnfeksiyonları Hakkında Kısa Bilgi
Bocavirus’un hastalık nedeni olduğu, ilk olarak 2005 yılında gösterilmiştir. Bocavirus, çocuklarda 5. Hastalık olarak bilinen hastalık tablosunu oluşturan Parvovirus B19 ile aynı virus ailesindendir ve benzerlik göstermektedir. Bocavirus infeksiyonlarında ateş, öksürük, solunum güçlüğü ortaya çıkmaktadır. Bocavirus infeksiyonu tanısı konulan ve hastaneye yatışı yapılan 18 hastanın 6’sında pnömoni, 8’inde bronşit, 2’sinde bronşiolit, 1’inde de laringotrakeit tablosu görülmüştür.
Domuz gribi vakalarının sayısı artıyor! Paniğe gerek var mı?
Bocavirusun, ağırlıklı olarak çocuklarda alt solunum yolu infeksiyonlarına neden olabileceği belirtilmektedir. Bocavirus ile ilgili araştırmaların, henüz yeterli düzeye ve bilgiye ulaşmadığı gözlenmektedir.
Bizim Verilerimizdeki Farklılıklar
- Bocavirus infeksiyonlarının solunum yolu infeksiyonlarındaki oranı Kanada’da %1.5, Japonya’da %5.7 olarak yer aldığı belirtilmiştir. Bizim bulgularımızda ise, oranlar daha yüksek olarak bulunmuştur. Oranlar %56’ya kadar yükselebilmektedir.
- Diğer araştırmalarda, Bocavirus infeksiyonlarının özellikle soğuk aylarda akut solunum infeksiyonu olarak ortaya çıkabileceği belirtilmektedir. Ancak bizim verilerimiz, tam tersine olarak, Mayıs ve Haziran aylarında ciddi bir artışı göstermektedir.
- Diğer bir farklılık, yaş ile ilgilidir. Bocavirus infeksiyonlarının, genelde 5 yaşın altındaki çocuklarda alt solunum yolu infeksiyonuna neden olabileceği belirtilmektedir. Ancak, bizim verilerimiz bu durumu tam olarak desteklemiyor.
DSÖ, Türkiye’yi de Zika virüsü için riskli ülkeler arasında ilan etti
Yaşları belirlenen 41 Bocavirus olgusunda, 23 (%56) hasta 0-10 yaş arasında, 5 (%12) hasta 10-20 yaş arasında, 13 (%32) hasta ise 20 yaş üzerindedir. 20 yaş üzerindeki 13 hastanın da, 11’i 38 yaş üzerinde, 7’si ise 73 yaş üzerindedir. Belirtilen bu yaşlar, Bocavirus infeksiyonları yönünden ilk defa telaffuz edilmektedir.
Sonuç olarak, Bocavirus infeksiyonlarının toplum yaşamımızda yer aldığını, hastalığın dünya ölçeğinde de tam olarak bilinmediğini, yeni bilgilere gereksinim duyulduğunu, bizim verilerimizin bu amaçla bazı katkılar sağladığını belirtebilecek durumdayız.
Prof. Dr. Paşa Göktaş
Tıp Laboratuvarları Derneği
Yönetim Kurulu Başkanı
tiplab@tiplab.org
YAZIYI PAYLAŞ


 Güncel verilere göre, yaz aylarına girdiğimiz son dönemde, Bocavirus Tip-1 infeksiyonlarında belirgin bir artış gözlenmektedir. Gelişim Tıp Laboratuvarları’na, mültipleks PCR yöntemiyle solunum yolu mikrobik etkenlerini belirlemek istemiyle 2016 Nisan’da 53, Mayıs’ta 51 ve Haziran’ın 17’sine kadar da 44 olmak üzere, toplamda 148 hastadan solunum yolu örneği gönderilmiştir. Nisan ayında 53 hastadan yalnızca 1 (%1.9) Bocavirus Tip-1 görülürken, Mayıs ayında bu sayı 17 (%56.8)’e yükselmiştir. Haziran’da solunum yolu örneği gönderilen 44 hastadan 25’inde Bocavirus Tip-1 saptanmıştır. Mayıs ve Haziran ayları itibariyle, Bocavirus infeksiyonlarında belirgin bir artış gözlenmektedir.
Güncel verilere göre, yaz aylarına girdiğimiz son dönemde, Bocavirus Tip-1 infeksiyonlarında belirgin bir artış gözlenmektedir. Gelişim Tıp Laboratuvarları’na, mültipleks PCR yöntemiyle solunum yolu mikrobik etkenlerini belirlemek istemiyle 2016 Nisan’da 53, Mayıs’ta 51 ve Haziran’ın 17’sine kadar da 44 olmak üzere, toplamda 148 hastadan solunum yolu örneği gönderilmiştir. Nisan ayında 53 hastadan yalnızca 1 (%1.9) Bocavirus Tip-1 görülürken, Mayıs ayında bu sayı 17 (%56.8)’e yükselmiştir. Haziran’da solunum yolu örneği gönderilen 44 hastadan 25’inde Bocavirus Tip-1 saptanmıştır. Mayıs ve Haziran ayları itibariyle, Bocavirus infeksiyonlarında belirgin bir artış gözlenmektedir. Ebola hastalığının nedeni virüs mü, yoksa eksik hijyen mi?
Ebola hastalığının nedeni virüs mü, yoksa eksik hijyen mi? Çocuklarda antibiyotik kullanımı, ailenin bilgi ve tutumu
Çocuklarda antibiyotik kullanımı, ailenin bilgi ve tutumu Domuz gribi vakalarının sayısı artıyor! Paniğe gerek var mı?
Domuz gribi vakalarının sayısı artıyor! Paniğe gerek var mı? DSÖ, Türkiye’yi de Zika virüsü için riskli ülkeler arasında ilan etti
DSÖ, Türkiye’yi de Zika virüsü için riskli ülkeler arasında ilan etti Laboratuvar testlerinin de bir maliyeti var!
Laboratuvar testlerinin de bir maliyeti var! Kışın sık hastalanan çocuklarda bazı tetkikler iyi yapılmalı…
Kışın sık hastalanan çocuklarda bazı tetkikler iyi yapılmalı… A’dan Z’ye Kanser ve kemoterapi yan etkileri hakkında temel bilgiler
A’dan Z’ye Kanser ve kemoterapi yan etkileri hakkında temel bilgiler
YORUMUNUZ VAR MI?